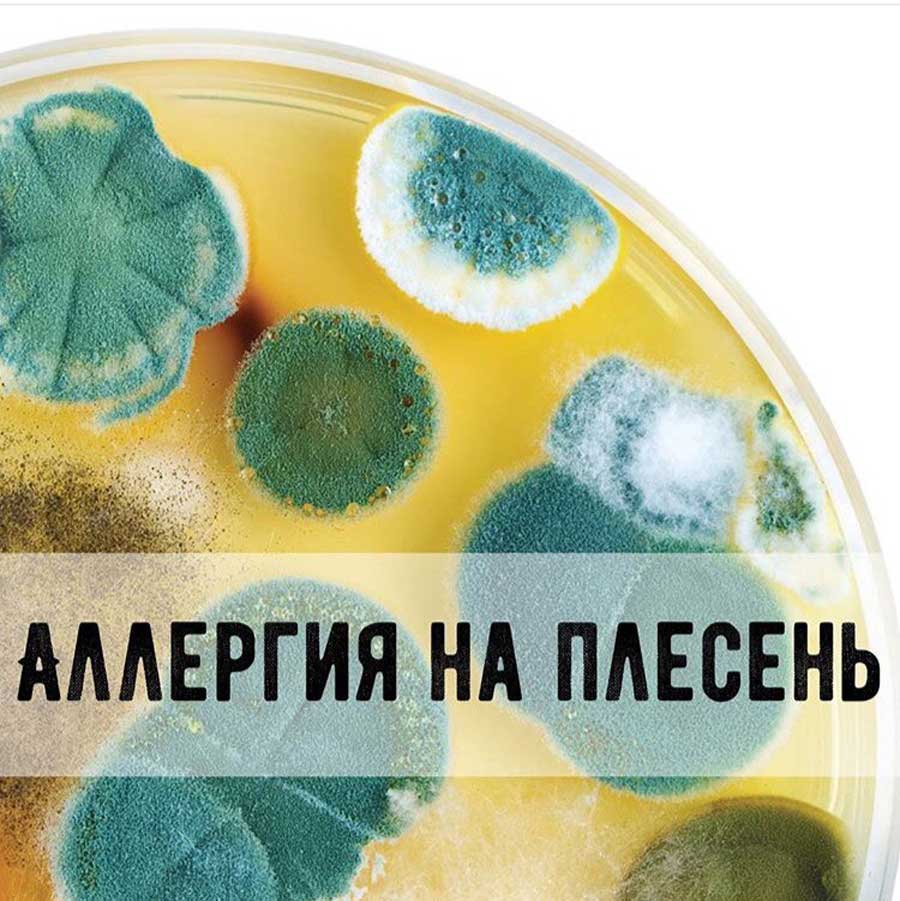
В Видном спасли подростка с аллергией на плесень

В подмосковном Видном врачи спасли подростка с сильной аллергической реакцией, вызванной плесенью в многоразовой бутылке для воды. Мальчик, страдающий с раннего возраста аллергией на плесень, долгое время не мыл бутылку и просто доливал в неё новую воду, не выливая старую. Это создало благоприятные условия для размножения грибка.

Источник:
Пациент поступил в Видновскую клиническую больницу с симптомами насморка, кашля и удушья. Для лечения ему назначили ингаляции с препаратами и антигистаминные средства, включающие блокаторы лейкотриеновых рецепторов, курсом на две недели. Медики предупреждают о важности регулярного ухода за многоразовыми ёмкостями, чтобы избежать подобных опасных последствий.
В регионе также фиксируют другие случаи отравлений у подростков, что подчёркивает необходимость усиленного контроля здоровья и санитарных условий среди молодёжи.
Источник: